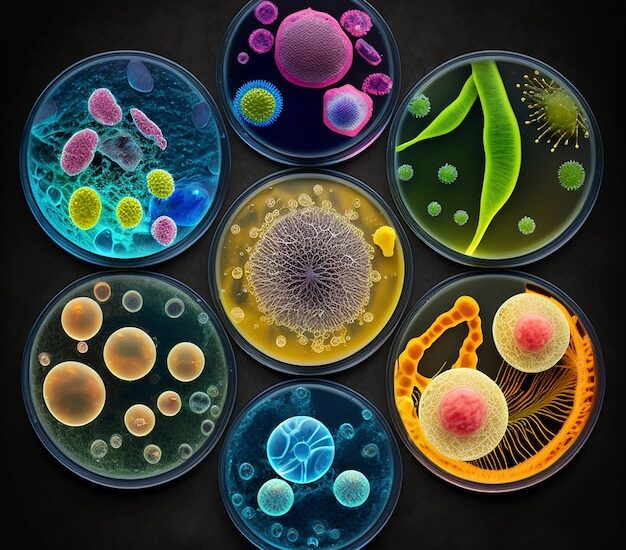
3D Cell Culture Market

The global 3D cell culture market is anticipated to account for a growth rate of around 9.8% over the forecast period from 2022 to 2031. The global market is expected to account for around US$ 1.15 Bn in 2022 and attain a valuation of US$ 2.67 Bn by 2031. According to the analysis done by Future Market Insights, the global 3D cell culture market accounted for a CAGR of 4.8% in 2021. During the historical period of 2016 to 2021, the 3D cell culture market expanded at a CAGR of 7.1%. According to the studies conducted by Future Market Insights, the comparative analysis along with the market growth rate of the global 3D cell culture market is expected to show a negative BPS growth in the H1-2022 outlook as compared to H1-2022 projected period by 10 BPS, However, a positive BPS growth is expected in H1-2022 over H1- 2021 duration with 02 Basis Point Share (BPS).
The global 3D cell culture market observes a drop in the BPS values owned to its disadvantage as compared to surface 2D cultures throughout the mass transfer process, thus making it a time-consuming and cost-incurring factor for manufacturers. Conversely, there is present, a phenomenal surge in the BPS value by 02 points indicating a positive market outlook. The rise in the BPS values is associated with the adoption of innovative cell culture devices for more predictive 3D models, thus promoting cost reduction, and limiting production times. The market is attributed to changes according to drug development and regulatory imposition, on the basis of the macro and industry-based dynamics.
Prepare To Thrive And Conquer New Horizons With Our Sample Report – Get It Now! https://www.futuremarketinsights.com/reports/sample/rep-gb-2843
Prominent development in the market incorporates scaffold-free 3D systems for stem-cell-derived therapies. 3D cell culture is known to create an artificial environment for the growth of cells in order to study their behavior in response to their given environment. 3D cell culture is expected to be defined as the culture of living cells that form a three-dimensional structure and mimic a tissue or an organ. 3D cell culture is excessively used for its convenience and innovative features in comparison to other cell culture methods. 3D cell culture is considered to be scaffold-free or scaffold-based 3D cell culture. Scaffolds are responsible for providing support to the cells. Surging focus on discovering alternatives in order to test animals, expanding focus on customized therapy, growing prevalence of chronic diseases, and increasing availability of research funding are all driving this market forward.
Key Takeaways
- 3D cell culture is known as a suitable alternative in translational and regenerative medicine since it represents a new, advanced, and robust platform for the investigation of complex biological procedures. 3D cell culture is projected to extend to various sectors of scientific research.
- Some improvements have taken place in tissue divergence and cell cohesion segments within the 3D cell culture market. These products are drastically becoming more popular and comprise more applications specifically in the early stages of drug development and other research & innovation.
- Researchers utilize this technology to create physiologically comparable cell cultures that aid in drug development and discovery. The persistent desire to improve efficiency in pharmaceutical R&D is also anticipated to promote the adoption of 3D cell culture products.
- A rising focus on exploring options for animal testing is anticipated to bolster market expansion. This is attributed to several regulatory bodies that have increased efforts to replace, reduce, and refine animals used in tests, as well as to provide rehabilitation for those animals. Non-animal models efficiently convert toxicological and pharmacology data to humans and are also predicted to support demand for alternatives to animal testing.
- Key researchers in the 3D cell culture market are going through tests to advance and create better options for cultivating cells and 3D cell culture provides a vast variety of advantages, including improved information and the ability to perform more effective research.
Our analyst is available to help you with any inquiries you may have @ https://www.futuremarketinsights.com/ask-question/rep-gb-2843
Competitive Landscape
Key 3D cell culture providers are innovating in products and focusing on new launches. Prominent manufacturers of 3D cell culture are offering a wide range of products.
Key Companies Profiled:
- 3D Biotek LLC
- Advanced Biomatrix Inc.
- Thermo Fisher Scientific Inc.
- Kuraray Co. Ltd.
- Lonza Group Ltd.
- Corning Incorporated
- Merck & Co. Inc.
- BiomimX SRL
- CN Bio Innovations
- Hurel Corporation
- InSphero AG
- MIMETAS BV
Key Segments of 3D Cell Culture Industry Survey
3D Cell Culture Market by Product:
- Scaffold-free 3D Cell Culture
- Scaffold-based 3D Cell Culture
3D Cell Culture Market by Application:
- Drug Discovery
- Tissue Regeneration & Regenerative Methods
- Cancer Research
- Stem Cell Technology
- Others
3D Cell Culture Market by End User:
- Biotechnology and Pharmaceutical Industries
- Hospital Laboratories
- Academic Research and Institutes
- Contract Research Organizations
Delivering Excellence Through Customization: Lessons from Our Report! https://www.futuremarketinsights.com/customization-available/rep-gb-2843
3D Cell Culture Market by Region:
- North America 3D Cell Culture Market
- Latin America 3D Cell Culture Market
- Europe 3D Cell Culture Market
- East Asia 3D Cell Culture Market
- South Asia & Pacific 3D Cell Culture Market
- Middle East & Africa (MEA) 3D Cell Culture Market
About Future Market Insights (FMI)
Future Market Insights, Inc. (ESOMAR certified, Stevie Award – recipient market research organization and a member of Greater New York Chamber of Commerce) provides in-depth insights into governing factors elevating the demand in the market. It discloses opportunities that will favor the market growth in various segments on the basis of Source, Application, Sales Channel and End Use over the next 10-years.
Contact Us:
Future Market Insights Inc.
Christiana Corporate, 200 Continental Drive,
Suite 401, Newark, Delaware – 19713, USA
T: +1-845-579-5705
For Sales Enquiries: sales@futuremarketinsights.com
Website: https://www.futuremarketinsights.com
LinkedIn| Twitter| Blogs | YouTube